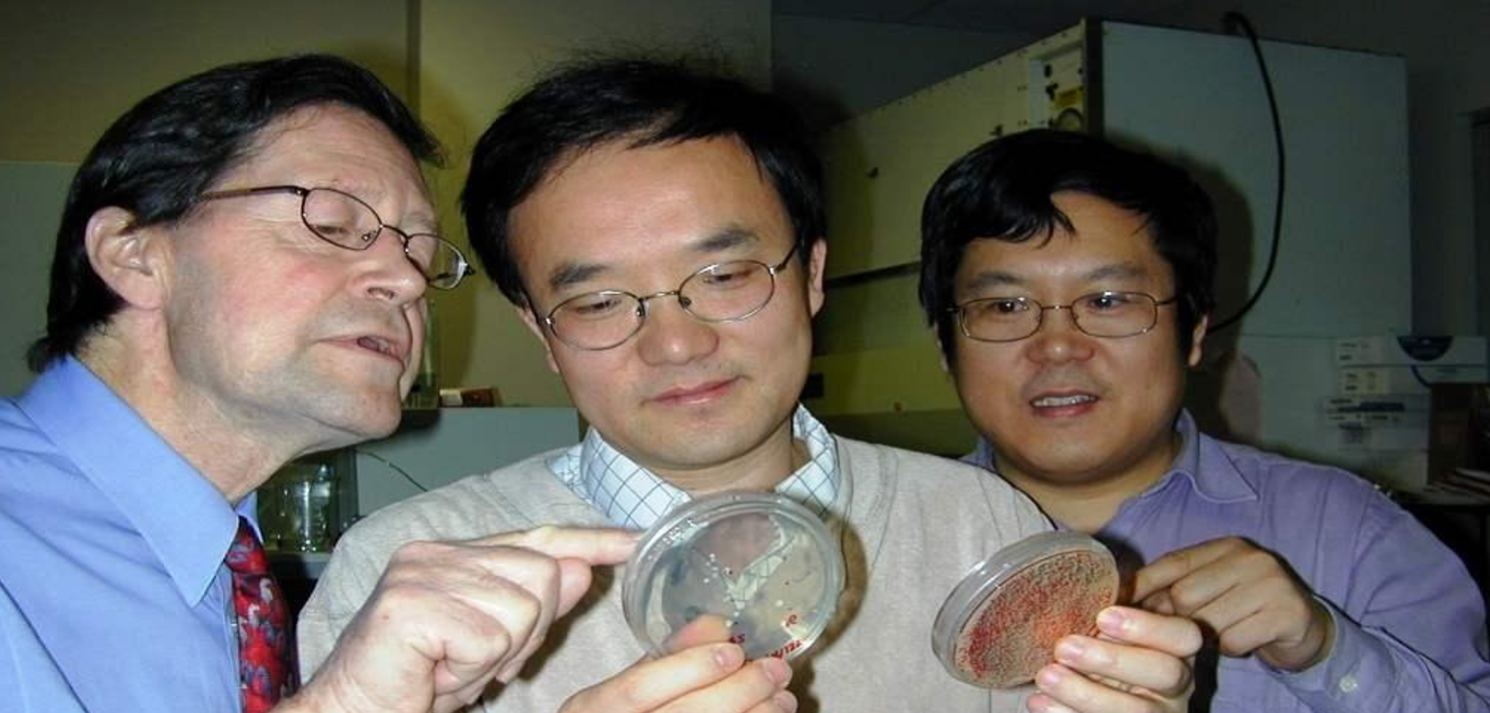

2024年11月,由上海澤德曼醫(yī)藥科技有限公司陳庚輝博士團隊主導研發(fā)的本維莫德乳膏(商品名:澤立美)在我國獲批上市,成為全球首個用于2歲及以上特應性皮炎患者的非激素外用創(chuàng)新藥。緊隨其后,美國Dermavant公司開發(fā)的同成分藥物Tapinarof乳膏(商品名:VTAMA)于同年12月獲FDA批準。盡管兩者核心成分相同,但在療效、價格及患者可及性上卻呈現(xiàn)顯著差異。

研發(fā)背景:中國原研,中美同源
本維莫德的發(fā)現(xiàn)可追溯至20世紀90年代,陳庚輝博士在加拿大西蒙弗雷澤大學研究時,發(fā)現(xiàn)異小桿線蟲共生菌產(chǎn)生的本維莫德具有抗炎特性。此后,他聯(lián)合創(chuàng)立加拿大Welichem公司并取得專利。2000年,本維莫德知識產(chǎn)權(quán)分屬中加兩地,陳庚輝博士回國在深圳創(chuàng)立天濟藥業(yè),與Welichem公司同步推進開發(fā)。2012年,葛蘭素史克(GSK)獲得海外開發(fā)權(quán)益,后于2018年轉(zhuǎn)售美國Dermavant公司。歷經(jīng)多年研發(fā),澤立美憑借本土化優(yōu)勢率先在中國上市,而VTAMA則成為美國市場的“高價新星”。
臨床試驗:療效和安全性相近,澤立美兒童群體表現(xiàn)更優(yōu)
根據(jù)III期臨床試驗數(shù)據(jù),澤立美與VTAMA在治療8周后均展現(xiàn)出優(yōu)異療效:
EASI75應答率:澤立美組54.4% vs VTAMA組55.8%;
IGA應答率:澤立美組46.2% vs VTAMA組45.4%。
值得注意的是,澤立美在7-11歲兒童患者中優(yōu)勢顯著,其EASI75應答率高達83.9%,遠超VTAMA的52.1%。安全性方面,兩者最常見不良反應均為毛囊炎,發(fā)生率分別為7.1%(澤立美)和9%(VTAMA),且多為一過性并呈輕中度,以皮膚局部不良反應為主。
價格差異:中國患者經(jīng)濟負擔更低
價格是中美兩國患者最直觀的對比項。
中國:澤立美每支售價980元人民幣;
美國:VTAMA單支售價約1400美元(約合人民幣9800元)。
從單支總價來看,美國市場的VTAMA價格約為中國澤立美的10倍。即使拋開包裝規(guī)格的不同,按克重換算,VTAMA價格仍為澤立美的2.5倍。這一懸殊差距使得中國患者能以更低成本獲得全球領(lǐng)先療法。
患者評價:“看得見的改善”成共同關(guān)鍵詞
從兩地患者社區(qū)反饋看,澤立美與VTAMA均收獲積極評價。
中國患者:多數(shù)澤立美使用者稱其“控制瘙癢、減輕紅斑、減少復發(fā)效果顯著”, 特別是對于一些使用激素效果不佳或擔心激素副作用的兒童患者,澤立美提供了一個新的、有效的選擇。
美國患者:在Reddit 社交平臺上分享使用體驗,認為VTAMA有效緩解了面部濕疹,瘙癢,和注射生物藥后復發(fā)的局部皮損。這種積極的使用體驗和對其效果的認可,也體現(xiàn)在了市場表現(xiàn)上。盡管價格高昂,但VTAMA在美國市場依然受到了歡迎,數(shù)據(jù)顯示,僅2025年第一季度,其銷售額就達到了2000萬美元,這從一個側(cè)面印證了美國患者對其療效的“買賬”程度。
總結(jié):中國澤立美更勝一籌
綜合來看,無論是中國的澤立美還是美國的VTAMA,由于核心活性成分(本維莫德)相同,其作用機制和臨床療效在很大程度上是相似且積極的,本維莫德為特應性皮炎患者提供了突破性治療方案。但中國澤立美是本維莫德發(fā)明人陳庚輝博士親自開發(fā)的,憑借原研優(yōu)勢、更優(yōu)的兒童療效、廣泛的患者認可及更親民的價格,與美國產(chǎn)品相比,更具性價比。陳庚輝博士團隊的成果讓廣大的中國特應性皮炎患者能夠以更低的價格,享受到全球領(lǐng)先的創(chuàng)新治療手段。